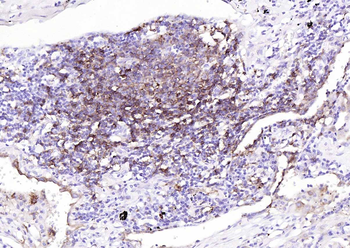

You have no items in your shopping cart.
Cart summary

Recombinant HLA-DR (MHC II) Antibody
Catalog Number: orb2310521
| Catalog Number | orb2310521 |
|---|---|
| Category | Antibodies |
| Description | Recombinant HLA-DR (MHC II) Antibody |
| Species/Host | Rabbit |
| Clonality | Monoclonal |
| Clone Number | HLA-DRA/8287R |
| Tested applications | IHC |
| Reactivity | Human |
| Isotype | IgG |
| Immunogen | Recombinant fragment (around aa1-200) of human HLA-DR protein (exact sequence is proprietary) |
| Antibody Type | Recombinant Antibody |
| Concentration | Purified Ab with BSA and Azide at 200ug/ml |
| Dilution range | Immunohistochemistry (Frozen & Formalin-fixed) (1-2ug/ml for 30 minutes at RT),(Staining of formalin-fixed tissues is enhanced by boiling tissue sections in 10mM Citrate Buffer, pH 6.0, for 10-20 min followed by cooling at RT for 20 minutes),Optimal dilution for a specific application should be determined. |
| Form/Appearance | 200ug/ml of Ab produced in HEK293 cell mammalian-based expression system. Prepared in 10mM PBS with 0.05% rAlbumin & 0.05% azide. Also available WITHOUT rAlbumin & azide at 1.0mg/ml. |
| Conjugation | Unconjugated |
| MW | ~28kDa (beta chain) |
| Target | HLA-DRA |
| Entrez | 3122 |
| UniProt ID | P01903 |
| Expression System | HEK293 cells |
| Storage | Maintain refrigerated at 2-8°C for up to 2 weeks. For long term storage store at -20°C in small aliquots to prevent freeze-thaw cycles. |
| Alternative names | DRB1; DRB4; HLA class II histocompatibility antige Read more... |
| Note | For research use only |
| Application notes | Positive Control: Human tonsil or lymph node |
| Expiration Date | 12 months from date of receipt. |
HLA-DR Recombinant Rabbit Monoclonal Antibody [orb783409]
ICC, IF, IHC-Fr, IHC-P, WB
Mouse, Rat
Human
Rabbit
Recombinant
Unconjugated
100 μl, 50 μlAnti-HLA-DR Reference Antibody (IMMU-114) [orb1817953]
ELISA, FC
Human, Monkey
Monoclonal
Unconjugated
100 μgCD74 Recombinant Rabbit Monoclonal Antibody [orb1816735]
FC, ICC, IF, IHC-Fr, IHC-P, WB
Human
Rabbit
Recombinant
Unconjugated
100 μl, 50 μlRecombinant CD74 (B-Cell Marker) Antibody [orb750994]
IHC, WB
Human, Mouse, Primate
Mouse
Monoclonal
Unconjugated
100 μgRecombinant CD74 (B-Cell Marker) Antibody [orb607918]
FC, IHC, WB
Human, Mouse, Primate
Rabbit
Monoclonal
Unconjugated
100 μg